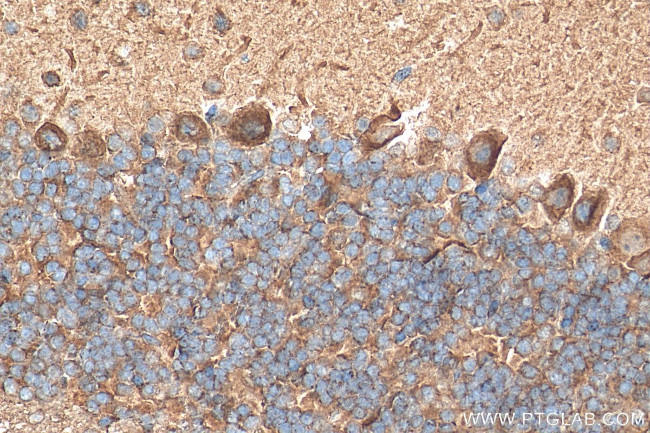
PSD95 Antibody in Immunohistochemistry (Paraffin) (IHC (P))

Search
Proteintech
PSD95 Recombinant Rabbit Monoclonal Antibody (1I22)
{{$productOrderCtrl.translations['antibody.pdp.commerceCard.promotion.promotions']}}
{{$productOrderCtrl.translations['antibody.pdp.commerceCard.promotion.viewpromo']}}
{{$productOrderCtrl.translations['antibody.pdp.commerceCard.promotion.promocode']}}: {{promo.promoCode}} {{promo.promoTitle}} {{promo.promoDescription}}. {{$productOrderCtrl.translations['antibody.pdp.commerceCard.promotion.learnmore']}}
图: 1 / 3
PSD95 Antibody (81106-1-RR100UL) in IHC (P)



产品信息
81106-1-RR100UL
种属反应
宿主/亚型
Expression System
分类
类型
克隆号
偶联物
形式
浓度
规格
纯化类型
保存液
内含物
保存条件
运输条件
靶标信息
Post Synaptic Density 95 kDa (PSD-95), also known as synapse associated protein 90 kDa (SAP90), is one of a family of membrane-associated proteins found in the postsynaptic density in forebrain neurons and certain presynaptic structures in the cerebellum. Like other members of the family, PSD-95 has three 90 amino acid repeats called PDZ domains followed by an SH3 domain and a yeast guanylate kinase homology (GuK) domain. PSD-95 is believed to participate in the clustering of certain proteins, including NMDA receptors, Shaker-type potassium channels at the synaptic membrane in central nervous system (CNS) neurons. There are two principal modes of interaction between PSD-95 and other proteins. NMDA receptors and shaker-type potassium channels both share C-terminal sequence homology consisting of a threonine/serine-X-valine-COOH (T/SXV) motif. Other neuronal proteins that share this motif (beta 1 adrenergic receptor, some serotonin receptors, some sodium channel subunits, and additional potassium channel subunits), and some of these proteins may interact with PSD-95 by binding to its PDZ domains. Neuronal nitric oxide synthase (nNOS), which lacks the T/SXV motif but which has its own PDZ domain, has been shown to associate with PSD-95 in vitro through a pseudo-homotypic PDZ-PDZ interaction.
仅用于科研。不用于诊断过程。未经明确授权不得转售。
篇参考文献 (0)
生物信息学
蛋白别名: discs large homolog 4; Disks large homolog 4; FLJ97752; FLJ98574; post synaptic density; post-synaptic density protein 95; Postsynaptic density protein 95; PSD-95; PSD-95 alpha 2b; PSD-95 beta; SAP-90; Synapse-associated protein 90; synapse-associated protein SAP90; Tax interaction protein 15; unnamed protein product
基因别名: DLG4; Dlgh4; MRD62; PSD-95; PSD95; SAP-90; SAP90; SAP90A
UniProt ID: (Human) P78352, (Rat) P31016, (Mouse) Q62108
Entrez Gene ID: (Human) 1742, (Rat) 29495, (Mouse) 13385